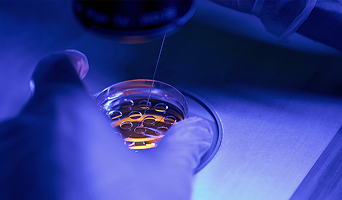
Preimplantation Genetic Diagnosis (PGD)

Preimplantation Genetic Diagnosis (PGD) in Philippines
Preimplantation genetic diagnosis, or PGD, is an advanced genetic testing technique performed on embryos during an IVF cycle to screen for specific inherited genetic conditions, chromosomal abnormalit...
70%
Cost Savings
About Preimplantation Genetic Diagnosis (PGD)
Everything you need to know before your procedure
Preimplantation Genetic Diagnosis (PGD)
Fertility Treatment
Overview
Preimplantation genetic diagnosis, or PGD, is an advanced genetic testing technique performed on embryos during an IVF cycle to screen for specific inherited genetic conditions, chromosomal abnormalities, or single gene disorders before implantation. It gives prospective parents the opportunity to select the healthiest embryos, significantly reducing the risk of passing on hereditary conditions and improving the chances of a successful pregnancy. Travelling abroad for PGD connects you with highly specialised fertility geneticists and state-of-the-art reproductive laboratories at considerably lower costs than at home. On CureMeAbroad, compare verified providers, explore top destinations, and review transparent pricing honestly. No commissions, no pressure, just clarity.
Why Choose Philippines for Preimplantation Genetic Diagnosis (PGD)?
Philippines is a leading medical tourism hub — here's why patients choose it
Up to 70% Cost Savings
Preimplantation Genetic Diagnosis (PGD) in Philippines costs significantly less than in Western countries — without compromising on quality.
JCI & Internationally Accredited Hospitals
Top hospitals in Philippines hold international accreditations ensuring world-class safety and care standards.
Highly Experienced Specialists
Philippines is home to surgeons with international training and thousands of Preimplantation Genetic Diagnosis (PGD) procedures performed.
All-Inclusive Medical Tourism
Combine your Preimplantation Genetic Diagnosis (PGD) with a full recovery in beautiful Philippines — flights, accommodation & aftercare included.
World’s No. 1 Medical Discovery Platform
CureMeAbroad
Is Absolutely Free
No sales. No commissions.
Just discovery so you can choose what's right for you!
Get Free Consultantion
Schedule Now
No sales. No commissions.
Just discovery so you can choose what's right for you!
Potential Risks
- Risk of miscarriage or pregnancy complications due to genetic issues
- Potential for failed fertilization or low-quality embryo development
- Chances of multiple births (twins, triplets, etc.) if more than one embryo is transferred
- Small risk of bleeding or infection during the procedure or in the early stages of pregnancy
- Emotional stress and anxiety related to the process and potential outcomes
Things to Check Before Booking
- ✓Discuss your medical history and any relevant allergies with the fertility clinic
- ✓Understand your insurance coverage for PGD procedures and any out-of-pocket costs
- ✓Research the clinic's success rates and reputation
- ✓Ensure you understand the process of freezing embryos and storing them for future use
- ✓Consult with your healthcare provider about potential emotional and psychological aspects of the procedure
Frequently Asked Questions
Preimplantation Genetic Diagnosis (PGD) in Philippines — common questions answered
Preimplantation Genetic Diagnosis (PGD) in Philippines is significantly more affordable compared to Western countries. Costs vary by clinic and complexity — contact us for a free quote.
Look for board-certified surgeons with international training and experience. CureMeAbroad has verified Preimplantation Genetic Diagnosis (PGD) specialists across top hospitals in Philippines. Use our platform to compare profiles and book a free consultation.
Yes. Philippines is one of the world's top medical tourism destinations with internationally accredited hospitals, English-speaking staff, and high patient satisfaction rates.
We recommend staying for at least 7–14 days post-procedure to allow for initial recovery and follow-up consultations before flying home.
Medical packages typically include consultation, the procedure, hospital stay, post-op care, and follow-up visits. Some packages also include airport transfers and accommodation. Contact our team for a full breakdown.
Medically Reviewed
CureMeAbroad Medical Review Team
This content has been reviewed and verified by the CureMeAbroad medical review team — a panel of board-certified specialists and internationally trained surgeons. Our team ensures all treatment information is accurate, up-to-date, and aligned with current clinical guidelines.
Help Me Plan
My
Preimplantation Genetic Diagnosis (PGD) Abroad
End to End Treatment Planning Specifically curated as per your need. Just a Call away

Book Your Free Medical Consultation
Get expert advice—free and easy. Start your healthcare journey today.

